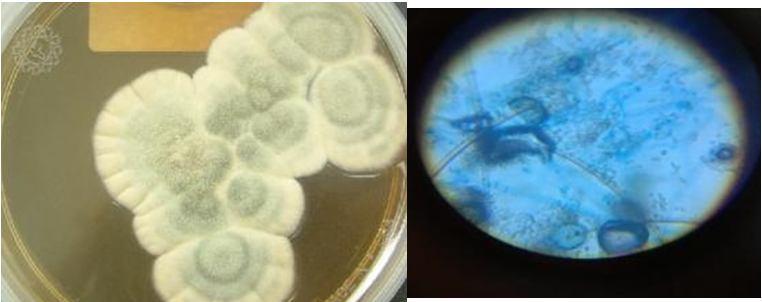
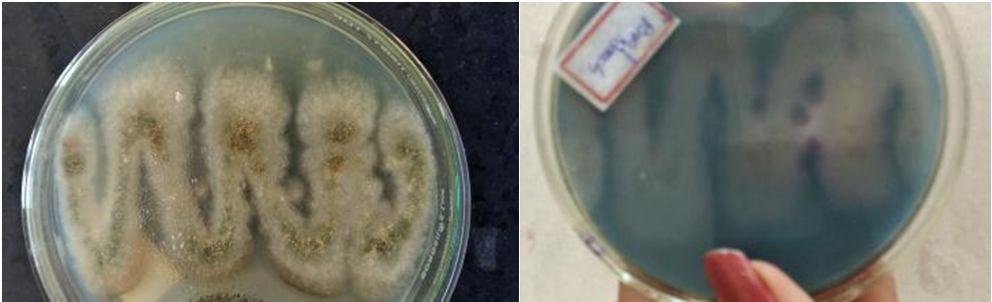
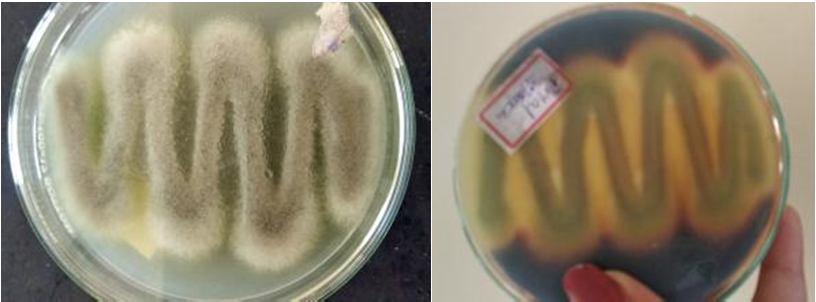
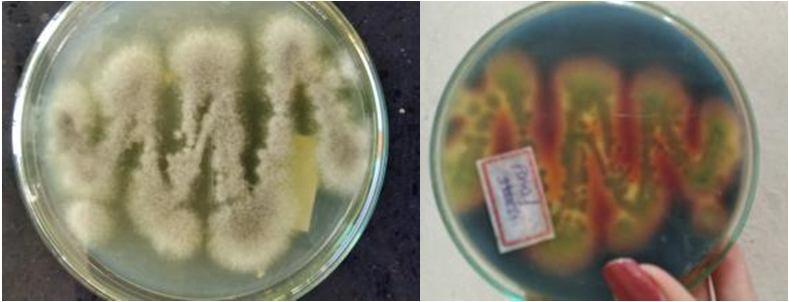
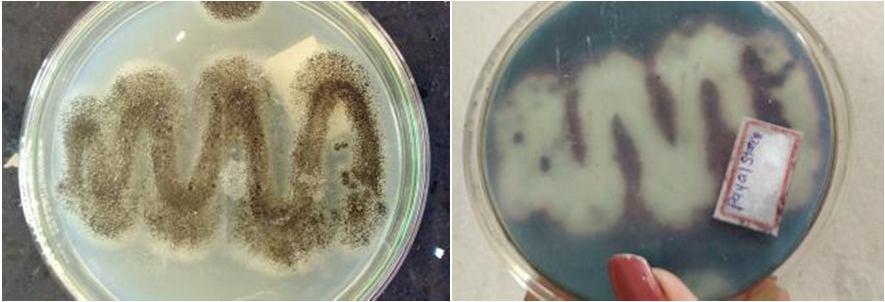

https://doi.org/10.22214/ijraset.2023.50004

ISSN: 2321-9653; IC Value: 45.98; SJ Impact Factor: 7.538

Volume 11 Issue III Mar 2023- Available at www.ijraset.com

https://doi.org/10.22214/ijraset.2023.50004

ISSN: 2321-9653; IC Value: 45.98; SJ Impact Factor: 7.538

Volume 11 Issue III Mar 2023- Available at www.ijraset.com
Abstract: Wood and lignocellulosic biomass is a low cost and abundant resource that can be used in the large scale production of fuels and chemicals. Lignocellulose can be converted into many products replacing products produced from fossil, such as bioenergy, biochemicals and biomaterial products through several treatment. In the bioethanol production, the lignin content in lignocellulose causes the conversion of cellulose to ethanol is less optimal. This research aimed to screen a number of fungal isolated from tropical forests to obtain the lignin-degrading fungi which are potentially used in lignocellulose biotreatment. The presences of covalent lignin carbohydrate linkage between sugar hydroxyl of hemicelluloses and phenylpropane subunits in lignin gives lignocellulose protection against degradation. Biofuel plays an essential role in replacing petroleum based fuels in current worldwide energy situation. The aim of the project is to identify new stain of fungi with high potential in degradation of lignin. The fungi is isolated from rotting wood piece for the study . Pereformed different methods to isolate the efficient fungi to degrade the lignin.
Keyword: Lignin, fungi, enzyme, rotten wood
Lignocelluloses are dermed as plant or wood cell walls within which cellulose is intimately related to lignin. additionally to those compounds, lignocellulose contains other polysaccharides. commonly called hemicelluloses. Lignocellulosic waste is that portion of the whole kingdom Plantae that's not properly employed for the welfare of human beings-mainly crop residues and wood and forestry wastes. the final chemical composition of those two groups differs basically in its cellulose and lignin portions. Crop residues contain 30-45% cellulose and 3-13% lignin. Wood residues contain higher amounts of both cellulose (45-56%) and lignin (18-30%) (zohar keren and yitzhak hadar lignin-Degrading Fungi: Mechanisms and Utilization ,The Hebrew University of Jerusalem, Rehovot, Israel,1997) lignocellulose has become a priority of the many researchers because it's the potential to be a source of primary renewable staple hence it will be used sustainably. Lignocellulose are often converted into many products replacing products produced from fossil, like bioenergy, biochemicals and biomaterial products . except for being renewable, products from lignocellulose also are environmentally friendly, for instance, the energy produced from bioethanol can reduce greenhouse emission emissions, and biomaterial products like bioplastics are often decomposed easily. it's different from the case when using products from fossil .(Idris*, I Ramadhani, A Kanti, and I M Sudiana Screening of potential lignin-degrading fungi from the tropical forest for lignocellulose biotreatment) In the plant cell lignin is biosynthesized from three hydroxycinnamyl alcohol monomers or monolignols: p-coumaryl alcohol, coniferyl alcohol and sinapyl alcohol . These monolignols (along with less abundant, acylated versions) are oxidatively coupled into lignin oligomers consisting of phenylpropanoid subunits: p-hydroxyphenol (H), guaiacyl (G) and syringyl (S) (from p-coumaryl alcohol, coniferyl alcohol and sinapyl alcohol, respectively). These three monolignols differ in their degree of methoxy group substitutions, which protect locations from the nonspecific radical coupling reactions that polymerize lignin . Consequently, the relative intracellular concentrations of the varied monolignols influence the resultant composition and structure of lignin in individual plants. as an example, grasses assemble lignin from G, S, and H monomers, hardwood contains roughly equal parts G and S, and softwood is up to 90% G . The linkages formed during radical coupling of lignin monomers varies between species and may be either C-C or C-O ether linkages, though typically over two-thirds of bonds are ether bonds.
The presence of lignin in lignocellulose causes this material to not decompose readily in nature. a fancy and rigid structure of lignin is that thereason why it's difficult to decompose . associated with the matter, some studies are trying to encounter those issues. one in every of them is utilizing ligninolytic fungi as lignin biodegrading agents in lignocellulose. Lignolytic fungi are a gaggle of fungi that are known to be ready to produce variety of enzymes which will break down the complex structure of the lignin polymer into simple molecules.

ISSN: 2321-9653; IC Value: 45.98; SJ Impact Factor: 7.538


Volume 11 Issue III Mar 2023- Available at www.ijraset.com
Generally, this enzyme was owned by many groups of rot fungi, specially white-rote fungi . Until now, many white rot fungi that are employed in lignocellulose processing. because the phenolic and β-hydrogen are shared between G, S, and H these sites participate in most of the bonding, with the β-aryl ether (e.g., β-O-4) linkage estimated to represent up to 80% of the bonding motifs found in lignin . polysaccharides of hemicellulose and cellulose to create the complex matrix, which provides the tissues and cell walls of all vascular plants strength, rigidity and protection from microbial degradation.(u.priyanga and m.kamahi, lignin degradation ,2018)
Lignin is made from three phenylpropane compounds or monolignols differing in methoxy substitutions. These monolignols are polymerized into corresponding phenylpropanoid monomeric units at any of the positions designated by a wavy bond. Since methylation limits available positions for polymerization, the relative abundance of every of the three monolignols dictates the structural and chemical properties of lignin derived from a plant species or tissue.

Lignolytic fungi are employed in lignocellulose biomass pretreatment for bioethanol production . Lignocellulose pretreatment using ligninolytic fungi was reported to be able to increase bioethanol production . aside from having the ability to extend the number of cellulose which will be converted, pretreatment using ligninolytic fungi also doesn't produce by products which will inhibit the reaction at a later stage.
Lignolytic fungi were also utilized in the biobleaching process within the paper industry moreover as in making compost and bioremediation of xenobiotic compounds . The biobleaching process can reduce the utilization of chlorine that's commonly used and reduce the assembly of waste material produced from the method.
The presence of ligninolytic fungi which have high lignin degradation activity can accelerate compost formation time, especially materials that have high lignin content which takes an extended time to decompose.(FNU Asina ,biodegradation of lignin by fungi,bacteria and laccase,2016)
There are many types of fungi which have the capacity to degrade lignin which humans can not digest these types of fungi produce enzymes like lignin peroxidase , magnesium peroxidase , laccase , this three enzymes have the ability to degrade lignin . In my project im taking a random sample of wood and try to isolated these type of fungi which degrade lignin identification done by microscopic and spore forming of fungi . mainly soft rot fungi , white rot fungi , brown rot fungi produce the enzymes which degrade lignin in wood . in my project from the wood sample here I isolate 10 different fungi and uses these fungi for further experiment to find from these fungi which fungi have the capacity to degrade lignin . so, in future these fungi can use to degrade lignin in low cost in industrial level so cellulose can be used to make fuels, chemicals , in paper industry etc.
A. Samples
Samples were procured for the isolation fungi which is capable for lignin degradation. Wood sample was collected from BKNMU campus. Aspergillus niger ,Penicillium chrysogenum , Phanerochaete chrysosporium was obtained from the rotten wood piece which is taken from out side the college gate of BKNMU. All the chemicals, reagents and media were prepared in distilled water. The prepared media was autoclaved at 15 lbs at 121o C for 20 minutes
A small part of rotten wood was directly kept on the SDA containing petri plates and incubated at room temperature for 10 days for the growth of fungi. After 10 days the petri plate was full of different different fungi . now trasfer the spores of fungi indivisually in different SDA petri plates for a pure fungi culture and incubate it for 7 days at room temperature. Different 10 fungi are incubated from the first plate of mixed fungi and use for further experiments.
Malt extract agar medium was prepared and methylene blue was added as a indicater and the test culture of pure fungi was transferred to the malt extract agar medium petri plates and incubated at room temperature for 10 days .
The fungi which produces the enzyme are detected by zones of discoloration of the methylene blue which was used as a indicator. The fungi was identified on the basis of their morphology, spore forming and by microscopic examination.

ISSN: 2321-9653; IC Value: 45.98; SJ Impact Factor: 7.538
Volume 11 Issue III Mar 2023- Available at www.ijraset.com
1) Starch Hydrolysis Test: Isolated fungal cultures was inculated onto the starch agar medium. The plates were here incubated at room temperature for 7 day . after 7 days the plates was flooded with iodine solution for 30 sec . examine the disappearances of starch from the starch agar medium plates.

2) Analysis of protein contain- Biuret method: Volumes sample, reagent can be scaled up/down and/or volume ratios varied, as with any assay. Warm up the spectrophotometer 15 min. before use. Prepare standards from bovine serum albumin, preferably calibrated using absorbance at 280 nm and the extinction coefficient. Using 5 ml color reagent to 1 ml sample a recommended range is 0.5 to 20 mg protein. Prepare a reference tube with 1 ml buffer. If possible, dilute unknowns to an estimated 1 to 10 mg/ml with buffer; a range of dilutions should be used if the actual concentration cannot be estimated. Use 1 ml sample per assay tube. Add 9 ml Biuret reagent to each tube, vortex immediately, and let stand 20 min. Read at 550nm (https://www.ruf.rice.edu/~bioslabs/methods/protein/biuret.html)

3) Estimation of reducing sugar-Dinitrosalicylic acid [ DNSA ]: Take test tubes labelled them. Make dilution of glucose standard and added to the test tube except blank Add 1 ml DNSA solution in each test tube and mix well. Keep in boiling water bath for 10 min. After cooling to room temperature add 8 ml distilled water in each test tube Take the OD at 540 nm.
A. Isolation of Fungi
After 10 days incubation different different fungi are seen in the SDA plates. 10 different fungi are taken or transfer in SDA plates for pure fungi culture.


10 different fungi are incubated for seven days and after 7 days pure fungi culture is ready for further experiments. Pure culture of fungi are observed under microscope for the identification . below is the fungi and microscopic view are given on the basic of which fungi are identified and names are given.










ISSN: 2321-9653; IC Value: 45.98; SJ Impact Factor: 7.538

Volume 11 Issue III Mar 2023- Available at www.ijraset.com


ISSN: 2321-9653; IC Value: 45.98; SJ Impact Factor: 7.538
Volume 11 Issue III Mar 2023- Available at www.ijraset.com
Aspergillus niger positive

Penicillium chrysogenum positive

Phanerochaete chrysporium positive
Aspergillus flavus positive
rhizopus negative
mucor negative
Aspergillus versicolor negative

Penicillium notatum negative



Table 5.1


ISSN: 2321-9653; IC Value: 45.98; SJ Impact Factor: 7.538
Volume 11 Issue III Mar 2023- Available at www.ijraset.com
FUNGI
RESULT
Aspergillus niger positive

Phanerochaete chrysosporium positive

Penicillium chrysogenum positive
Aspergillus flavus negative

ISSN: 2321-9653; IC Value: 45.98; SJ Impact Factor: 7.538
Volume 11 Issue III Mar 2023- Available at www.ijraset.com




ISSN: 2321-9653; IC Value: 45.98; SJ Impact Factor: 7.538
Volume 11 Issue III Mar 2023- Available at www.ijraset.com
(blue-aspergillius,green-penicillium,red-phanerochante)
Conclusion - Penicillium chrysogenum gives maximum result means the protein contain is maximum in Penicillium chrysogenum as compared to other fungi and as we compared with the fungi’




ISSN: 2321-9653; IC Value: 45.98; SJ Impact Factor: 7.538
Volume 11 Issue III Mar 2023- Available at www.ijraset.com
Graph for std -

blue- aspergillus, green- pencillium, red- Phanerochaete chrysosporium
Conclusion: penicillium chrysogenum gives better result as compared to other fungi as we compared with the std.

[1] Andrzej leonowicz, anna matuszewska, jolanta luterek, dirk ziegenhagen, maria wojtas-wasilewska, nam-seok cho, martin hofrichter and rogalski ,1999, Biodegradation of lignin by white rot fungi.
[2] Adrika raybarman , kazi atikur rahman , russel miranda vincent , sayantani chatterjee, upasana sen , arup kumar mitra , sudeshnashyam choudhury , ridhi majumder, 2014, isolation and characterisation of lignin degrading fungus from coir
[3] Ahmed M. Abdel-Hamid, ... Isaac K.O. Cann, in Advances in Applied Microbiology, 2013
[4] Adya P. Singh, ... Tripti Singh, in Secondary Xylem Biology, 2016
[5] Ejaz Ahmad, Kamal K. Pant, in Waste Biorefinery, 2018
[6] FNU Asina ,biodegradation of lignin by fungi,bacteria and laccase,2016
[7] Frank K. Ko, ... John F. Kadla, in Lignin in Polymer Composites, 2016
[8] Geoffrey Daniel, in Secondary Xylem Biology, 2016
[9] https://scolar.google.com
[10] https://www.sciencedirect.com
[11] https://en.m.wikipedia.org
[12] https://shodhganga.inflibnet.ac.
[13] Idris*, I Ramadhani, A Kanti, and I M Sudiana Screening of potential lignin-degrading fungi from the tropical forest for lignocellulose biotreatment
[14] Jean-Claude Sigoillot, ... Eva Uzan-Boukhris, in Advances in Botanical Research, 2012
[15] Jersson Plácido & Sergio Capareda Bioresources and Bioprocessing volume 2, Article number: 23 (2015)
[16] Miia R. Mäkelä, ... Jaana Kuuskeri, in Reference Module in Life Sciences, 2020
[17] M. Tuomela, A. Hatakka, in Comprehensive Biotechnology (Second Edition), 2011
[18] M. Abhilash, D. Thomas, in Biopolymer Composites in Electronics, 2017
[19] P. Giardina, ... G. Sannia, in Progress in Biotechnology, 2002
[20] Ramesh C. Ray, Sudhanshu S. Behera, in Biotechnology of Microbial Enzymes, 2017
[21] Rosane Marina Peralta, ... Adelar Bracht, in Biotechnology of Microbial Enzymes, 2017
[22] Robert A. Zabel, Jeffrey J. Morrell, in Wood Microbiology (Second Edition), 2020
[23] S.keerthana, p. kalaiselvi, m.maheshwari and t. kalaiselvi, 2019, isolation and screening of lignin and cellulose degrading proficient microbial strain from diverse biotic substrates based on qualitative trait.
[24] Tarun shekhawat ,2014, isolation and characterization of lignin degrading microbes
[25] Thelmo A. Lu-Chau, ... Gemma Eibes, in Bioethanol Production from Food Crops, 2019
[26] u.priyanga and m.kamahi, lignin degradation ,2018

[27] Ahmed M. Abdel-Hamid, ... Isaac K.O. Cann, in Advances in Applied Microbiology, 2013
[28] Z. Yue, J. Economy, in Activated Carbon FiberandTextiles2017
[29] Zohar kerem , yitzhak hada , 1997, lignin degrading fungi mechanism and utilization.
